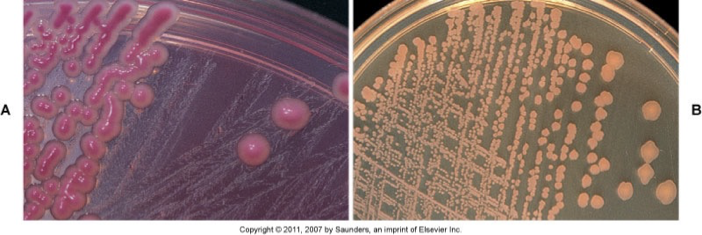
<p><span><strong><span>Selective:</span></strong><span> Bile salts and crystal violet inhibit gram-positive bacteria. Grows only gram-negative bacilli</span></span></p><p><span><strong><span>Differential:</span></strong><span> Based on lactose fermentation. Pink = lactose fermentation. Clear = no lactose fermentation. Neutral red dye is a pH indicator. Colonies turn pink in acidic pH, clear in basic pH</span></span></p>

1/153
Looks like no tags are added yet.
Name | Mastery | Learn | Test | Matching | Spaced | Call with Kai |
|---|
No analytics yet
Send a link to your students to track their progress
What are the four major microbes?
Viruses,Bacteria, Fungi, and Parasites

What type of cell is this?
Eukaryotic

What type of cell is this?
Prokaryotic
What are the characteristics of Eukaryotic Cells?
characterized by the presence of a membrane-bound nucleus and chromosomal, linear DNA. They also frequently have other organelles, such as mitochondria, lysosomes, ribosomes, and golgi bodies. They sometimes have cell walls. These organisms can be either single-celled or multicellular, and they can reproduce asexually (through binary division) or sexually.
What are the characteristics of Prokaryotic cells?
DO NOT have a membrane-bound nucleus, and their genome is a single, circular chromosome. They have ribosomes in their cytoplasm but do not contain any other organelles. They are always unicellular and reproduce exclusively asexually.

What Acellular host is this?
Virus
What are the key characteristics of viruses?
Acellular. Not actually considered living. Asexual reproduction. Single-stranded or double-stranded RNA or DNA. Size: too small to be seen with most microscopes
What are the key characteristics of bacteria?
Prokaryotic. Unicellular. Asexual reproduction. Circular genome. Size: not visible to the naked eye, but can be view microscopically
What are the key characteristics of Fungi?
Eukaryotic. Unicellular or multicellular. Asexual or sexual reproduction. Size: Varied microscopic single-celled yeast to large multicellular mushrooms

What are the key characteristics of Parasites?
Eukaryotic
Unicellular of multicellular
Asexual or sexual reproduction
Size: Varied The range in size from tiny, single-celled protozoa to large, 50-foot long tapeworms.

What are all the routes of transmission?
Airborne, Food and Water, Close contact, Cuts and Bites, Arthropods, Zoonoses, and Fomite
How is Airborne transmission spread?
Aerosolized respiratory secretions – coughing, sneezing, talking
What is the prevention against airborne transmission?
Natural Prevention: ciliary epithelium/nose hairs, secretory IgA, lysozyme, alveolar macrophages, mucus, skin. Additional prevention: cover mouth, good hygiene, quarantine, ventilation, vaccination
How is Food and Water transmitted?
Fecal-oral route
What are some preventions against fecal-oral route transmission?
Natural Prevention:normal flora protects, gastric enzyme/acidity, vomiting, diarrhea. Additional prevention: good sanitation and hygiene, proper disposal, cooking and washing food, not allowing sick person to handle food prep
How is close contact transmitted?
Passage of organisms by salivary, skin and genital contact. Generally sexually transmitted infections
How can we prevent close contact transmission?
Natural Prevention: Skin, secretory IgA, lysozyme, mucus, inflammation, normal flora. Additional prevention: good hygiene, “don’t touch,” protective barriers
How are Cuts and Bites transmitted?
Whenever we have a break in our skin, our most important barrier to infection, we are susceptible to infection. Both humans and animals carry potentially pathogenic organisms in their saliva
What is the prevention against cuts and bite transmission?
Skin is most important barrier to infection.
How are arthropods transmitted?
Infection as a result of a tick, flea, or mite bite. Microorganisms multiply in arthropod and during feeding on human arthropod transmits microorganism
How is Zoonoses spread?
Contact with animals or animal products. Ex: contact with secretions or carcasses
Disease of animals that is transmitted to humans
How do fomites spread organisms?
Any inanimate object or substance capable of carrying infectious organisms
Symbiosis
Two or more organisms where both the host and organism benefit from one another
Commensalism
The organism benefits but there is no beneficial or harmful effect to the host
Parasitism
Organism benefits at the expense of the host
What are the Host Resistance Factors?
Physical barriers, Cleaning mechanisms, Antimicrobial substances, Inflammation, Phagocytosis, and Immune responses
What are some characteristics Normal Flora?
Commonly found on or in body sites of healthy persons. Organisms present are influenced by the nutritional and environmental factors – pH or oxygen. Resident flora – colonize area for months or years. transient flora – present temporarily (just visiting). Provides host resistance to infections. Opportunistic pathogens – do not cause disease in healthy host but can in individuals with compromised immune systems

characteristics of Pathogenic organisms?
Ability of a microbe to produce disease. True pathogen. Cause disease in healthy/immune-competent individuals
Ex: Yersinia pestisand Bacillus anthracis
What does Virulence mean?
Degree of pathogenicity. Measured by the numbers of microorganisms necessary to cause infection
Amount of organism necessary to cause infection:
Salmonella – thousands or Shigella – less than 100
Which organism is more virulent? Shigella
Virulence factors: Allow the pathogen to overcome host defenses and cause disease
How does Resisting Phagocytosis happen?
Evade phagocytic cells such as macrophages and polymorphonuclear cells. Capsule on the surface (most common) –Protein A. Release toxins.

How does an organism adhere to Host Cells?
Adhesins – mediate attachment. Fimbriae – more per cell and shorter in length; both gram-positive and gram-negative. Pili – less per cell but longer; only gram-negative; also help with gene transfer. Surface polysaccharides
Enable bacteria to adhere to host cell surface
Exotoxin
Produced within cell and released to surrounding areas. Produced by gram-negative and gram-positive bacteria. Can mediate direct spread of organism. Cause cell and tissue damage. Can cause systemic effects if carried through blood stream
Endotoxin
Are a constituent, the lipopolysaccharide (LPS), of the outer cell membrane of gram-negative bacteria. Antigenic O – specific polysaccharide. Core polysaccharide. Inner lipid A – endotoxin. Can cause: clotting, changes in blood pressure, temperature, neutropenia, activates complement
Bacterial Genetics
Bacterial genome: Single, circular piece of DNA. Asexual reproduction. Genetic alterations: Plasmids – Extrachromosomal, circular pieces of DNA; passed from bacteria; carry virulence genes or antibiotic resistance genes. Transposons – “jumping genes,” transferred from organisms and can be inserted into genome; antibiotic resistance. Mutations – mistake in DNA replication

Genetic transfer of DNA between bacteria through mechanisms of conjugation.

Cocci shaped bacteria that can be found in various arrangements, such as clusters or chains.

Bacilli are rod-shaped bacteria that can occur singularly or in chains.

Spirochetes
Gram-positive bacteria have a what type if thick layer?
Very thick peptidoglycan layer
Gram-negative have a what kind of inner layer?
Outer membrane – lipopolysaccharides, phospholipids, proteins. Inner peptidoglycan layer
Acid fast bacteria have what kind of cell wall?
Gram-positive cell wall structure plus waxy layer of glycolipids and fatty acids bound to exterior cell wall
What are the steps in the gram staining process?
Stain characteristics determined by the cell wall structure
Reagents: 1.Crystal violet – primary stain 2.Iodine – mordant 3.Acetone – decolorizer 4.Safranin – counterstain
Gram-positive bacteria – stain purple. Gram-negative bacteria – stain pink
Nonselective media
Contains appropriate nutrients for growth of most bacteria
Selective Media - Selects for bacteria with specific traits
Gram reaction, Nutrient utilization, and Antibiotic resistance
Differential media
Allows for grouping microbes based on color or colony morphology on the medium
Enriched media
Contains extra nutrients needed by microbes with special nutritional requirements

5% Sheep Blood Agar
Nonselective
Differential
Hemolysis of red blood cells

MacConkey Agar
Selective: Bile salts and crystal violet inhibit gram-positive bacteria. Grows only gram-negative bacilli
Differential: Based on lactose fermentation. Pink = lactose fermentation. Clear = no lactose fermentation. Neutral red dye is a pH indicator. Colonies turn pink in acidic pH, clear in basic pH
Columbia-Colistin Naladixic Acid Agar (CNA)
Selective: Antibiotics inhibit growth of gram-negative bacteria
Differential: Can detect hemolysis of red blood cells
Chocolate Agar
Nonselective and Enriched
Intracellular nutrients allows for growth of fastidious organisms such as Haemophilus and pathogenic Neisseria

Thioglycollate Broth
Enriched broth mediumCan identify bacteria by where they grow in the broth
Strict aerobes grow only at the top
Facultative organisms grow throughout
Anaerobes grow at the bottom
Microaerophiles grow in the middle

Staphylococci = Streaming in thio broth
Streptococcus = “puff balls in thio broth

Gram negative bacilli = overall turbidity in thio broth

Culture incubation conditions for air and duration in time
Atmospheric conditions: Ambient air, CO2 – 5%-10%, and Microaerophilic – Lower O2, Higher CO2 Anaerobic
Duration: Dependent of speed of growth of common organisms from particular site
24-72 hours most
Culture Incubation for temp and humidity
Temperature: 4ºC – Refrigerator Temperature – used for selectivity. 25ºC – Room Temperature. 30ºC – for fungus. 35ºC – Standard incubation temperature – close to human body temp. 42ºC – Used for selectivity
Humidity – at least 70%
What are the modes of action for antibiotics?
Inhibition of bacterial cell wall synthesis, Inhibition of folate synthesis, Inhibit protein synthesis, Inhibit nucleic acid synthesis, and (DNA replication or RNA polymerase)
Susceptibly Diffusion testing Methods
Kirby Bauer and E-Test
Susceptibly Dilution testing Method
Microdilution
Broad-spectrum antibiotics
Effective against a larger number of organisms
Narrow-spectrum antibiotics
Effects a limited number of organisms
Bacteriostatic
inhibit bacterial growth but do not kill the organism
Bactericidal
exert lethal effects on microorganisms
What is the Ideal Antibiotic?
Exhibits selective toxicity. No host sensitivity or allergy. No toxicity at serum or plasma drug concentrations needed to eliminate microorganisms. Water soluble. Not readily secreted by the kidneys or metabolized by the liver. Minimal cost
Natural Bacteria resistance
Common to all members of a given species
Acquired resistance in bacteria
Found in only some members of a species. Can be acquired through mutation or genetic transfer. Altering antibiotic target sites, creating enzymes that dismantle antibiotics, or decrease cell wall permeability
Bacteria Resistance Mechanisms
Impermeability – antibiotic cannot pass cell wall. Biofilm production – group of bacteria live as part of a matrix of bacteria that irreversible attach to a surface. Efflux pumps: remove toxins from inside the cell. Enzymatic inactivation – breaking down antibiotics. Target site mutationT – altering the target site of the antibiotic
Susceptibility Testing - When and Why?
Performed on pathogenic organisms. To determine which antimicrobial agents are effective for treatment
Factors to consider when determining if potential pathogen: Body site, specimen quality, and Host Status
Susceptibility Testing – Which drugs?
Determined by organism characteristics: intrinsic resistance or Acquired resistance
Infection site: Urine vs. wound vs. blood
Cost and toxicity of antimicrobial agents
Quantitative Susceptibility Interpretation
Minimum Inhibitory Concentration (MIC)
Lowest concentration of an antimicrobial agent required to inhibit the growth of a bacterial isolate. Measured in µg/mL
Qualitative Susceptibility Interpretation
Susceptible – Organism is inhibited at normally-prescribed doses
Intermediate – Organism may be inhibited with higher dose or in body sites where the drug is concentrated
Resistant – Organism will not be inhibited with biologically-achievable levels
Susceptibility Testing – How?
From pure culture
Standardization: Media, Antibiotic concentration, Number of bacteria, Using McFarland Standard to ensure no false susceptibility or false resistance
What 2 groups of antibiotics inhibit cell wall synthesis?
Beta-lactam and Gylcopeptides
What antibiotic inhibit folate synthesis?
Sulfonamides
What antibiotics inhibit RNA synthesis?
Rifamycin
What antibiotics inhibit DNA synthesis
Fluoroquinolones and Quinolones
What group of antibiotics inhibit protein synthesis
Aminoglycosides, Tetracyclines, Macrolides and Oxazolidinones
What antibiotic drugs are in beta-lactam group and what main type of gram bacteria dpes it work on?
Penicillins (gram pos) semisynthetic like ampicillin, amoxicillin, methicillin, or oxacillin, cephalosporins, carbepenems like meropenem or imipenem, and monobactams. Broad spectrum except for penicillin and bactericidal (kills bacteria)
What antibiotic drugs are in Glycopeptides group and what type of gram bacteria does it affect?
Glycopeptides like vancomycin primarily target gram-positive bacteria. Narrow spectrum and bactericidal (kills bacteria)
What antibiotic drugs are in Sulfonamides groups and what type of gram bacteria does it affect?
Synthetic molecules, trimethoprim, and sulfamethoxazole. They primarily target both gram-positive and gram-negative bacteria. Broad-spectrum and bacteriostatic (inhibit bacterial growth)
What antibiotic drugs are in Quinolones and Fluoroquinolones groups and what type of gram bacteria does it affect?
Ciprofloxacin, nalidixic acid, and levofloxacin. Targets both gram pos and gram neg bacteria. Is broad spectrum and bactericidal (kills bacteria).
What antibiotic drugs are in Rifamycins and what does it best treat?
Rifampin is best used for CSF and abscesses, because it penetrates the tissues. Narrow spectrum and bactericidal
What antibiotic drugs are in Aminoglycosides and what gram bacteria does it work on?
Streptomycin, gentamicin, and tobramycin. Target gram neg and gram pos bacteria. Broad spectrum and bactericidal (kills bacteria).
What are the antibiotic drugs in Tretracylines and what type of gram bacteria does it impact?
Tetracyline and sem-synthetic form of doxycycline. Effective against gram pos and some gram neg bacteria; broad spectrum and bacteriostatic (inhibits growth).
What are the antibiotic drugs in macrolides group and what gram bacteria does it affect?
Erythromycin, clarithromycin, and azithromycin. Effective against gram pos bacteria and some gram neg; broad spectrum and bacteriostatic.
What are the antibiotic drugs in Oxazolidinones groups and what gram bacteria does it work on?
Linezolid is the primary antibiotic in the oxazolidinone class. It is effective against gram-positive bacteria, including resistant strains like MRSA and VRE; it is bacteriostatic. Narrow spectrum
Intestinal and Tissue Helminths
Enterobius vermicularis – Pinworm, Ascaris lumbricoides, Necator americanus and Ancylostoma duodenale – hookworm, Trichinella spiralis, Trichuris trichiura – whipworm, Strongyloides stercolaris – threadworm, and Dracunculus medinensis – Guinea worm

Pinworm – Enterobius vermicularis life cycle
Pinworm what population is affected, symptoms, and diagnosis
Most common in children
Symptoms. Many asymptomatic: Perianal itchiness
Diagnosis. Pinworm paddle, Look for eggs
Most common helminth infection in the US

Pinworm eggs

Ascaris lumbricoides life cycle
What is the population infection and symptoms for Ascaris lumbricoides?
Distribution – worldwide. Just under 1 billion people currently infected. Most common helminth in the world
Symptoms: Generally asymptomatic, Malabsorption, Abdominal discomfort, Loss of appetite, and Intestinal obstruction. Diagnostic stage – eggs or adult worms

Ascaris lumbricoides fertilized

Ascaris lumbricoides unfertilized

Hookworm – Necator americanus and
Ancylostoma duodenale life cycle
Distribution and symptoms of Hookworm?
Distribution: Both in Africa, Asia, Australia, and Americas
Necator americanus – South India & predominates Americas
Ancylostoma duodenale – Middle East, North Africa, and northern India. Over 500 million infected worldwide
Symptoms: Itching at site of skin penetration – ground itch, Cough, sore throat, mild pneumonia, Nausea, diarrhea, vomiting, Iron deficiency anemia, and Blood loss

Hookw

Trichinella spiralis life cycle
Distribution, symptoms, and diagnosis for Trichinella spiralis?
Distribution – worldwide among meat-eating populations
Symptoms: Intestinal phase (1st week): Nausea, vomiting, diarrhea, abdominal pain. Migration phase (lasts 1 month): High fever, periorbital edema, cough, chest pain, sometimes death, increased eosinophil count. Muscular phase: Localized pain, inflammation, and edema
Diagnosis: Tissue biopsy

Trichinella spiralis

Whipworm – Trichuris trichiura life cycle